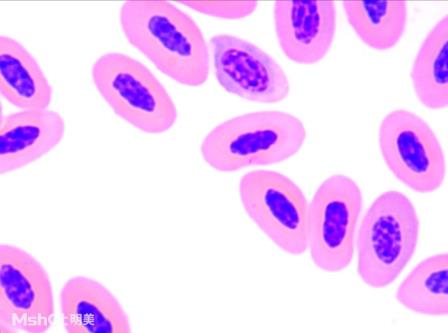

生物顯微鏡 ML30
產(chǎn)品描述
實拍圖片

薺菜幼胚
產(chǎn)品參數(shù)
項目 |
規(guī)格 |
目鏡 |
WF10X/20 |
目鏡筒 |
30傾斜,瞳距調(diào)節(jié)55-75mm,三目鏡,五五分光 |
物鏡 |
無限遠平場消色差物鏡?4X/0.10? |
無限遠平場消色差物鏡?10X/0.25 |
|
無限遠平場消色差物鏡?40X/0.65 |
|
無限遠平場消色差物鏡?100X/1.25 |
|
轉(zhuǎn)換器 |
四孔轉(zhuǎn)換器 |
載物臺 |
雙層機械式載物臺210mm×140mm;移動范圍75mm×50mm |
調(diào)焦機構(gòu) |
粗微調(diào)同軸,配有限位裝置和鎖緊裝置,微調(diào)手輪格值2μm |
透射照明系統(tǒng) |
6V20W?鹵素?zé)?,亮度可調(diào),內(nèi)置視場光闌 |
阿貝聚光鏡,可上下升降,NA1.25 |
|
(藍、磨砂玻璃)濾色片轉(zhuǎn)換裝置 |
|
相機接口 |
1XC |
資料下載
相關(guān)產(chǎn)品







